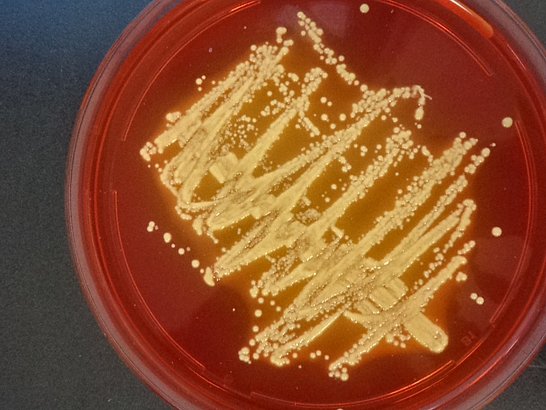

Gesellschaften der Dermapharm Unternehmensgruppe
Wer wir sind
Die mibe GmbH Arzneimittel als Tochterunternehmen der Dermapharm AG entwickelt und produziert mit über 700 Mitarbeitern an ihrem hochflexiblen, modernen und leistungsfähigen Standort in der Mitte Deutschlands. Im Großraum Leipzig/Halle werden insbesondere Arzneimittel, aber auch Kosmetika und Nahrungsergänzungsmittel gefertigt. Die mibe bekennt sich damit eindeutig zum Produktionsstandort Deutschland. Innerhalb des Dermapharm Konzerns ist die mibe GmbH Arzneimittel der größte Produktionsstandort für Arzneimittel. Von unserem Standort heraus erfolgt der zentrale Versand der Produkte der Firmengruppe an deutsche und österreichische Großhändler und Apotheken, an Großhändler in Kroatien, an Läger in der Schweiz, Polen, Italien, Spanien, Frankreich sowie auch in außereuropäische Regionen.

Qualitätsmanagement
Die Qualität unserer Arzneimittel hat für uns oberste Priorität.
Beginnend mit einem gezieltem Auswahlverfahren zum Einkauf unserer Ausgangs- und Verbrauchsmaterialien, über die Wareneingangskontrollen, den während des Herstellungsvorganges durchzuführenden (In)Prozesskontrollen, der Freigabeanalytik und den begleitenden Stabilitätsuntersuchungen bis hin zur Betreuung von auf dem Markt befindlichen Waren, behalten wir unsere Produkte über Ihren Lebensweg im Blick.
Durch unsere hochmodernen Labore, in denen wir 97% unserer Analysen im Hause durchführen können, gewährleisten wir, dass wie unsere Produkte routinemäßig auf sehr hohem Standard und in kurzer Zeit freigeben können.
Wir verfügen selbstverständlich über die entsprechenden Erlaubnisse und Zertifikate, wie z.B.
- Herstellungserlaubnis nach AMG
- Großhandelserlaubnis nach AMG
- Zertifikat über die Übereinstimmung eines pharmazeutischen Herstellers mit GMP-Artikel 111 (5) der Richtlinie 2001/83/EC


Logistik & Versand
Aus unserem zentralen Versand- und Logistikzentrum in Brehna hinaus versenden wir den Großteil der Arzneimittel und der weiteren Präparate für die Dermapharm Unternehmensgruppe an Apotheken und Großhändler in Deutschland und Österreich.
Ein paar Kennzahlen:
- 27.000 Palettenstellplätze über 6000 Kommissionierflächen
- Ca. 1850 Pakete / Tag
- Ca. 45 Paletten / Tag
- Lieferzeit in Apotheken 24 h / Großhändler 48 h